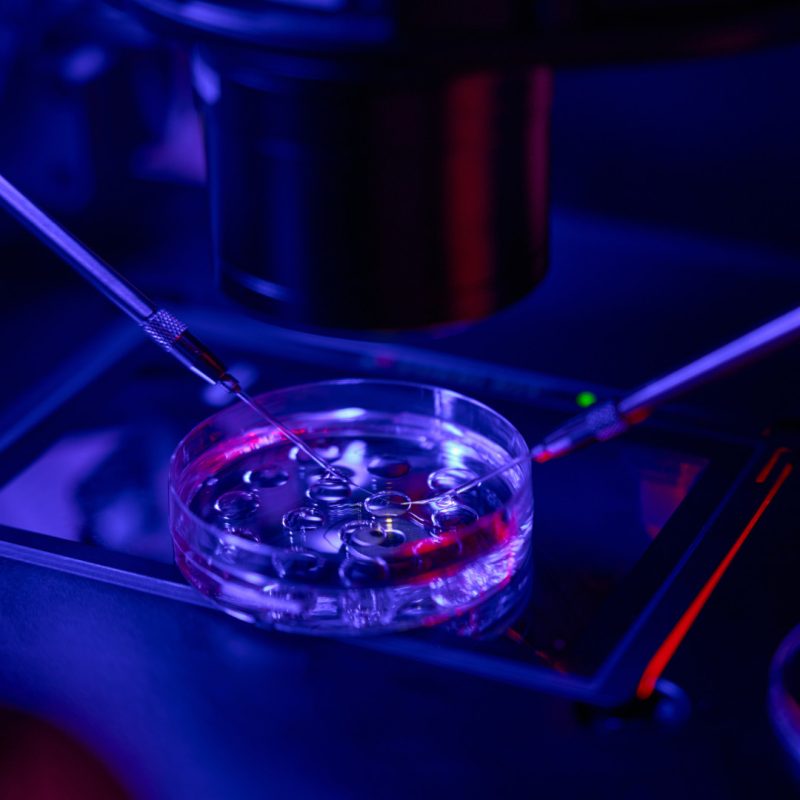
PMA Eterologa a Bologna - Clinica Fecondazione Assistita Omniclinics

- Chi Siamo
- Ginecologia
- Riproduzione
- Diagnosi Prenatale
- Aree Mediche
- Specialisti
- Eventi
- News
- Contatti
- Prenota
PMA Eterologa
Realizzare il sogno della genitorialità
Fecondazione con donazione di ovuli e spermatozoi
La PMA Eterologa rappresenta una strada concreta e sicura per tutte quelle coppie che, a causa di specifiche problematiche di fertilità, non possono utilizzare i propri gameti (ovociti e spermatozoi) per il concepimento.
In Omniclinics Bologna affrontiamo questo percorso con la massima sensibilità e rigore scientifico, garantendo l’accesso a programmi di donazione di ovociti e spermatozoi di altissima qualità, selezionati secondo i più severi standard internazionali.

A differenza della PMA Omologa, la Procreazione Medicalmente Assistita di tipo eterologo prevede l’impiego di gameti (ovociti o spermatozoi) provenienti da un donatore esterno alla coppia.
Questa tecnica è indicata quando uno o entrambi i partner presentano un’assenza di gameti, una qualità cellulare non idonea o il rischio di trasmettere malattie genetiche ereditarie. In Italia, questo percorso è regolamentato e accessibile, offrendo alle coppie la possibilità di vivere l’esperienza della gravidanza e della genitorialità.
In base alle necessità cliniche diagnosticate, il percorso di PMA Eterologa per Omniclinics Bologna può declinarsi in tre modalità principali:
PMA Eterologa Femminile
La Procreazione Medicalmente Assistita con ovodonazione è la tecnica indicata quando la donna non può utilizzare i propri ovociti (ad esempio per menopausa precoce, ridotta riserva ovarica o precedenti interventi).
In questo percorso clinico, gli ovociti della donatrice vengono fecondati in vitro con il seme del partner. Gli embrioni ottenuti vengono poi trasferiti nell’utero della paziente, opportunamente preparato a riceverli.
PMA Eterologa Maschile
La fecondazione assistita con donazione dello sperma viene impiegata in presenza di gravi patologie del seme maschile (azoospermia) o anomalie genetiche che non permettono l’uso del liquido seminale del partner.
Nella PMA eterologa maschile, il seme di un donatore selezionato viene utilizzato per fecondare gli ovociti della partner, sia tramite inseminazione intrauterina (IUI) che tramite fecondazione in vitro (FIVET/ICSI).
PMA Eterologa con Doppia Donazione
Questa tecnica di PMA viene consigliata quando entrambi i partner presentano problematiche di infertilità che impediscono l’uso dei gameti della coppia. In questo caso, si utilizzano sia ovociti che spermatozoi da donatori esterni.
Garanzia e sicurezza: la selezione dei donatori
La sicurezza dei nostri pazienti è la priorità assoluta. Per il servizio di PMA Eterologa a Bologna, Omniclinics collabora con le più prestigiose banche dei gameti europee, assicurando che ogni donatore sia sottoposto a:
Intraprendere un percorso di PMA eterologa richiede non solo figure mediche specializzate, ma anche un supporto emotivo costante. Affidarsi alla nostra clinica significa poter contare su:
Se desideri maggiori informazioni sulla PMA Eterologa a Bologna in Omniclinics e vuoi conoscere le percentuali di successo dei nostri trattamenti, siamo pronti ad ascoltare le tue esigenze.

L’età massima consentita per l’accesso alla PMA è generalmente di 46 anni (ma può variare da regione a regione) per un massimo di 6 cicli di trattamento. L’età minima invece è di 18 anni.
Oltre all’età anagrafica, ci sono altre condizioni cliniche e normative: possono accedere alla PMA le coppie sposate o conviventi in modo stabile che hanno ottenuto un accertamento dello stato di infertilità o di sterilità.
Una serie di esami clinici che certificano l’impossibilità della coppia di arrivare a una gravidanza in modo naturale. Si ottiene tramite una serie di esami diagnostici specialistici, che solitamente iniziano da una visita ginecologica o andrologica.
La diagnosi di infertilità è una delle condizioni necessarie per richiedere l’accesso alla PMA.
Anche se la procreazione medicalmente assistita non rientra nei termini dell’aspettativa retribuita è comunque possibile ottenere un periodo di assenza retribuita dal lavoro (INPS – Messaggio n. 7412 del 4 marzo 2005).
Considerando il periodo del ricovero e quello post dimissioni, vengono concessi 21 giorni di malattia in totale.
Il congedo può essere richiesto tramite la clinica che ha effettuato gli interventi di PMA.
PRENOTA UNA VISITA
Il nostro Staff è qui per ascoltarti, rispondere alle tue domande o metterti in contatto con lo Specialista più indicato alle tue esigenze.
